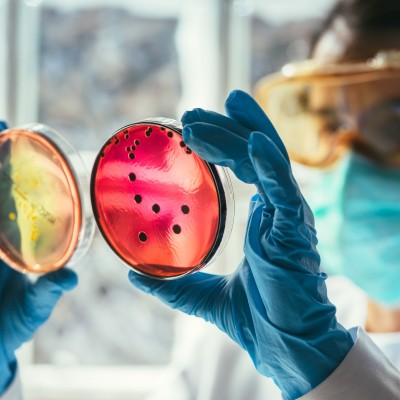

-
8 March 2024
On International Women’s Day 2024 Nina Nugent, Programme Lead for the Greater Manchester Diagnostics Network shares her thoughts on this year's 'Invest in women: Accelerate progress' theme.
-
8 June 2023
To celebrate Biomedical Science Day 2023 I wanted to do this blog to share the ongoing work of the GM Pathology Network around workforce.
-
8 March 2023
On International Women’s Day, Leighan Beesley, Digital Diagnostics System Lead for the Grater Manchester Imaging Network shares her thoughts on working in a digital role for the NHS.
-
10 February 2023
For International Day of Women and Girls in Science, Katie Moss, Programme Director for the GM Imaging and Pathology Networks shares her experience of being in the scientific community, and how she has progressed her career.
-
28 December 2022
In this blog, Chris Sleight, Chief Officer for the GM Imaging Network shares his insight from attending the King's Fund conference in November.
-
14 December 2022
In this blog post Dr Rajesh Rajendran, Associate Medical Director (Infection Control) and Clinical Head of Division of Laboratory Medicine at Manchester University NHS Foundation Trust explains the role pathology plays when dealing with an increase in infections such as Group A Strep. Manchester University NHS Foundation Trust is a member of the Greater Manchester Pathology Network.
-
8 November 2022
In this blog post, Elaine Quick, PACS Implementation Lead for the Greater Manchester Imaging Network and a previous Radiography Service Manager, explains why we mark World Radiography Day.
-
24 October 2022
Chris Sleight, Chief Officer, Greater Manchester Imaging Network provides insight into the NHS Radiology Conference 2022.